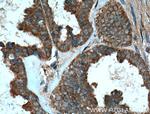
MMP23B Antibody in Immunohistochemistry (Paraffin) (IHC (P))

Search
Proteintech
MMP23B Polyclonal Antibody
{{$productOrderCtrl.translations['antibody.pdp.commerceCard.promotion.promotions']}}
{{$productOrderCtrl.translations['antibody.pdp.commerceCard.promotion.viewpromo']}}
{{$productOrderCtrl.translations['antibody.pdp.commerceCard.promotion.promocode']}}: {{promo.promoCode}} {{promo.promoTitle}} {{promo.promoDescription}}. {{$productOrderCtrl.translations['antibody.pdp.commerceCard.promotion.learnmore']}}
产品信息
13020-1-AP
种属反应
宿主/亚型
分类
类型
抗原
偶联物
形式
浓度
规格
纯化类型
保存液
内含物
保存条件
运输条件
产品详细信息
Immunogen sequence: QGDVAALGL SAVPPTRVPG PLAPRRRRYT LTPARLRWDH FNLTYRILSF PRNLLSPRET RRALAAAFRM WSDVSPFSFR EVAPEQPSDL RIGFYPINHT DCLVSALHHC FDGPTGELAH AFFPPHGGIH FDDSEYWVLG PTRYSWKKGV WLTDLVHVAA HEIGHALGLM HSQHGRALMH LNATLRGWKA LSQDELWGLH RLYGCLDRLF VCASWARRGF CDARRRLMKR LCPSSCDFCY EFPFPTVATT PPPPRTKTRL VPEGRNVTFR CGQKILHKKG KVYWYKDQEP LEFSYPGYLA LGEAHLSIIA NAVNEGTYTC VVRRQQRVLT TYSWRVRVRG (52-390 aa encoded by BC025719)
靶标信息
MMP23B (matrix metallopeptidase 23B) is also named as MMP21, MMP22. It is a regulator in matrix remodeling and may be playing a role in enchondral bone formation and in regulation of cranial suture closure. It has 3 isoforms produced by alternative splicing with the molecular weight of 44 kDa, 48 kDa and 46 kDa, respectively. It also can be N-glycosylated.
仅用于科研。不用于诊断过程。未经明确授权不得转售。
生物信息学
蛋白别名: Femalysin; matrix metallo protease; matrix metalloproteinase 22; matrix metalloproteinase 23B; matrix metalloproteinase in the female reproductive tract; Matrix metalloproteinase-21; Matrix metalloproteinase-22; Matrix metalloproteinase-23; MIFR-1; MMP; MMP 23; MMP-21; MMP-22; MMP-23; MMP23; MMPs; RP11-345P4.2; unnamed protein product
基因别名: MIFR; MIFR-1; MMP21; MMP22; MMP23A; MMP23B
UniProt ID: (Human) O75900
Entrez Gene ID: (Human) 8511, (Human) 8510